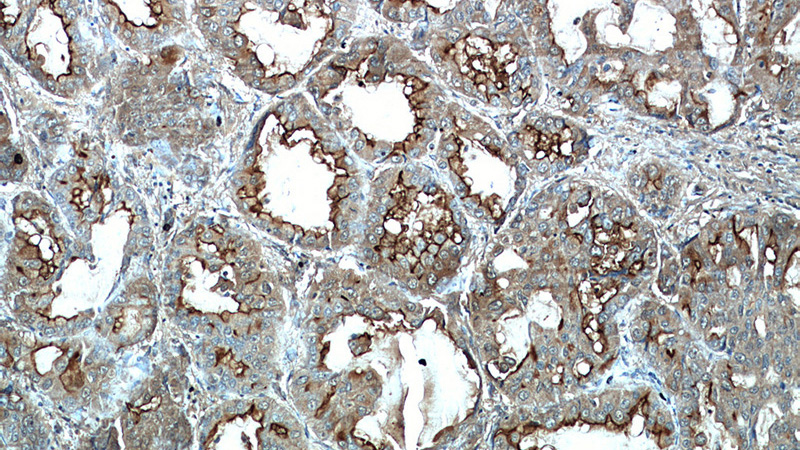
Immunohistochemical of paraffin-embedded human lung cancer using Catalog No:112888(CA15-3,MUC1 antibody) at dilution of 1:50 (under 10x lens)
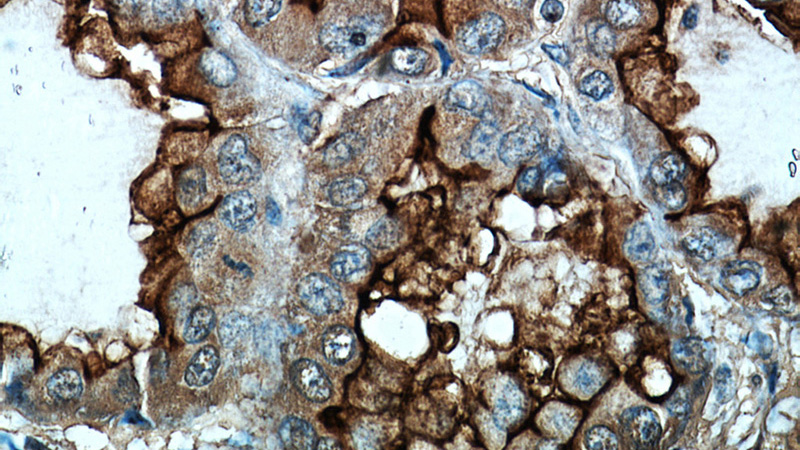
Immunohistochemical of paraffin-embedded human lung cancer using Catalog No:112888(CA15-3,MUC1 antibody) at dilution of 1:50 (under 40x lens)

-
Product Name
MUC1/CA15-3 antibody
- Documents
-
Description
MUC1/CA15-3 Rabbit Polyclonal antibody. Positive IHC detected in human lung cancer tissue, human breast cancer tissue, human meningioma tissue, human ovary tumor tissue. Positive FC detected in MCF-7 cells. Positive IP detected in A431 cells. Positive WB detected in A431 cells. Observed molecular weight by Western-blot: 122 kDa
-
Tested applications
ELISA, WB, FC, IHC, IP
-
Species reactivity
Human; other species not tested.
-
Alternative names
CA15 3 antibody; Carcinoma assOCiated mucin antibody; CD227 antibody; EMA antibody; Episialin antibody; H23AG antibody; KL-6 antibody; MAM6 antibody; MUC 1 antibody; MUC1 antibody; MUC1 beta antibody; MUC1 CT antibody; MUC1 NT antibody; Mucin 1 antibody; Peanut reactive urinary mucin antibody; PEM antibody; PEMT antibody; Polymorphic epithelial mucin antibody; PUM antibody; Tumor assOCiated mucin antibody
-
Isotype
Rabbit IgG
-
Preparation
This antibody was obtained by immunization of Peptide (Accession Number: J05582). Purification method: Antigen affinity purified.
-
Clonality
Polyclonal
-
Formulation
PBS with 0.02% sodium azide and 50% glycerol pH 7.3.
-
Storage instructions
Store at -20℃. DO NOT ALIQUOT
-
Applications
Recommended Dilution:
WB: 1:500-1:5000
IP: 1:200-1:2000
IHC: 1:20-1:200
-
Validations
Immunohistochemical of paraffin-embedded human lung cancer using Catalog No:112888(CA15-3,MUC1 antibody) at dilution of 1:50 (under 10x lens)

1X10^6 MCF-7 cells were stained with 0.2ug CA15-3,MUC1 antibody (Catalog No:112888, red) and control antibody (blue). Fixed with 90% MeOH blocked with 3% BSA (30 min). Alexa Fluor 488-congugated AffiniPure Goat Anti-Rabbit IgG(H+L) with dilution 1:1000.
Immunohistochemical of paraffin-embedded human lung cancer using Catalog No:112888(CA15-3,MUC1 antibody) at dilution of 1:50 (under 40x lens)

A431 cells were subjected to SDS PAGE followed by western blot with Catalog No:112888(CA15-3,MUC1 antibody) at dilution of 1:1500

IP Result of anti-CA15-3,MUC1 (IP:Catalog No:112888, 4ug; Detection:Catalog No:112888 1:700) with A431 cells lysate 1520ug.
-
Background
MUC1, a type I transmembrane glycoprotein, belongs to the family of mucin proteins which are expressed by various epithelial cell types. It consists of a very large extracellular domain, a trans-membrane domain, and a short cytoplasmic tail. Among the known mucins, MUC1 is best studied and plays crucial roles in regulating many cellular properties, including cell proliferation, apoptosis, adhesion, and invasion. MUC1 primarily functions in lubrication and hydration of epithelia and protection from microbial attack. It also has been implicated in progression of numerous types of cancer.
-
References
- Zhan XX, Zhao B, Diao C, Cao Y, Cheng RC. Expression of MUC1 and CD176 (Thomsen-Friedenreich antigen) in papillary thyroid carcinomas. Endocrine pathology. 26(1):21-6. 2015.
Related Products / Services
Please note: All products are "FOR RESEARCH USE ONLY AND ARE NOT INTENDED FOR DIAGNOSTIC OR THERAPEUTIC USE"
